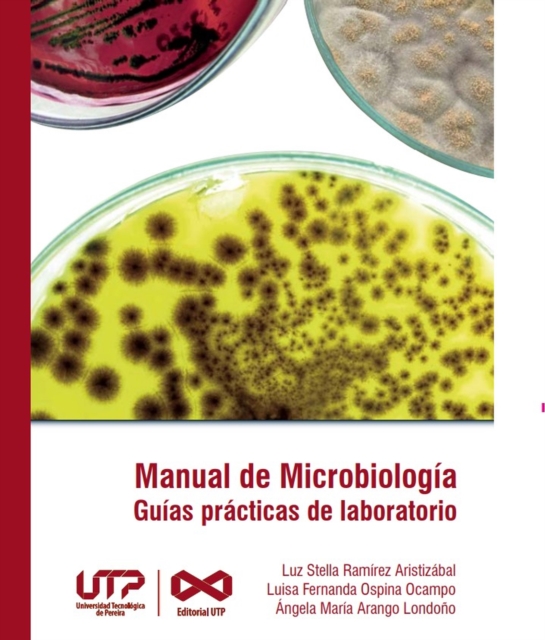
Manual de Microbiologia, guias practicas para laboratorio

Manual de Microbiologia, guias practicas para laboratorio
Available
En el momento donde se hace necesario migrar a la virtualidad, surge como una oportunidad de innovacion en el laboratorio la creacion de un manual no solo de practicas academicas, relacionadas con fundamentos generales de microbiologia, sino una publicacion que implementa metodologias para la solucion de casos mediante softwares o simuladores virtuales, que complementan el aprendizaje basado en pr...
Read more
E-book
pdf
Price
3.99 £
En el momento donde se hace necesario migrar a la virtualidad, surge como una oportunidad de innovacion en el laboratorio la creacion de un manual no solo de practicas academicas, relacionadas con fundamentos generales de microbiologia, sino una publicacion que implementa metodologias para la solucion de casos mediante softwares o simuladores virtuales, que complementan el aprendizaje basado en pr...
Read more
Follow the Author
